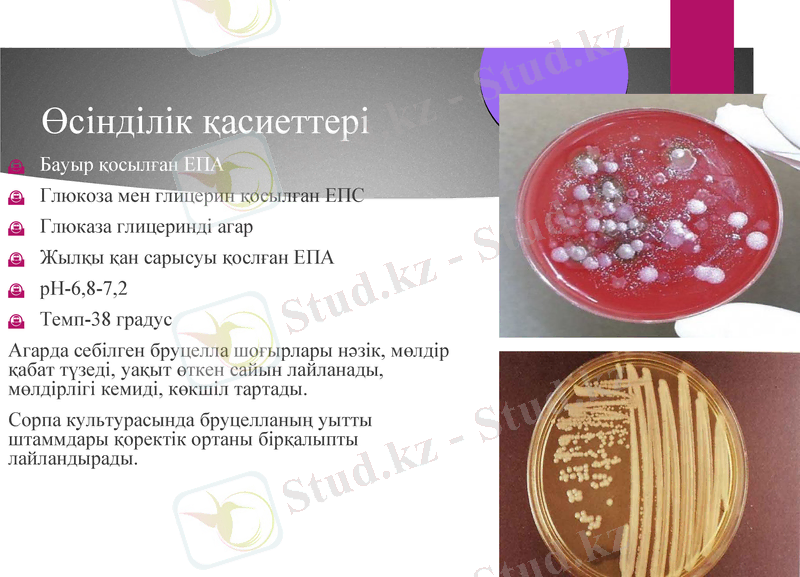
Slide 7

Бруцеллез: этиологиясы, клиникасы және диагностикалық әдістері



БӨЖ
Тақырыбы: «Бруцеллез және оны балау әдістері»
2015ж
ҚАЗАҚСТАН РЕСПУБЛИКАСЫ БІЛІМ ЖӘНЕ ҒЫЛЫМ МИНИСТРЛІГІ
СЕМЕЙ ҚАЛАСЫНЫҢ ШӘКӘРІМ АТЫНДАҒЫ МЕМЛЕКЕТТІК УНИВЕРСИТЕТІ
АГРАРЛЫҚ ФАКУЛЬТЕТ «ВЕТЕРИНАРИЯЛЫҚ САНИТАРИЯ» КАФЕДРАСЫ
Орындағандар: ВС-303
Акимжанова Марал
Тексерген: Нуркенова М. К.

Бруцеллёз (мальта қызбасы) .
Бұл ауру осы аурумен ауыратын малдың сүтін ішуден болады. Ол сондай-ақ терідегі жырындылар мен жаралар арқылы организмге тарайды, бұл жағдай ауру малдарды күтіп-бағатын адамдарда жиі кездеседі, сонымен қатар ауру зақымданған ауамен демалған кезде тыныс жолдары арқылы да денеге түседі.

Этиологиясы
Бруцеллез - бруцеллалармен шақырылатын қоздырғышы әртүрлі механизммен берілетін, клиникасында созылмалы қызбамен, қимыл-қозғалыс аппаратының, жүйке-жүйесінің, жүрек-қан тамыр жүйесінің, зәр шығару жүйесінің және т. б жүйелердің зақымдалуымен жүретін, созылмалыға ауысуға бейім, инфекция-аллергиялық, зоонозды инфекциялық ауру.



Морфологиясы
Грам теріс боялады, ұсақ, полиморфты, кокк тәріздес немесе қысқа таяқша түріндегі микроорганизм.
Мөлшері 0, 5*0, 7-0, 6*1, 5мкм
Спора түзбейді, қозғалмайды.
Өсінділік қасиеттері
Бауыр қосылған ЕПА
Глюкоза мен глицерин қосылған ЕПС
Глюказа глицеринді агар
Жылқы қан сарысуы қослған ЕПА
рН-6, 8-7, 2
Темп-38 градус
Агарда себілген бруцелла шоғырлары нәзік, мөлдір қабат түзеді, уақыт өткен сайын лайланады, мөлдірлігі кемиді, көкшіл тартады.
Сорпа культурасында бруцелланың уытты штаммдары қоректік ортаны бірқалыпты лайландырады.

Эпидемиологиясы

Бруцеллалар ағзаға тері немесе шырышты қабаттар арқылы енеді, сосын макрофактормен ұсталып, сол жерде көбейеді де, лимфа ағынымен регионарлық лимфа түйіндеріне енеді. Содан соң қан тамырлар арқылы бүкіл ағзаға жайылады. Патогенезінде инфекцияның дамуы 5 фазадан өтеді:
лимфогенді фаза
гематогенді фаза
көп ошақты себу жайылу фазасы
экзоошақты себу фазасы
метомффоз фазасы
Әр фазаның көрінуі және олардың дамуы организмнің индивидуальды ерекшелігіне байланысты, кіру жеріне, түріне қоздырғыш дозасына және зақымдану шартына байланысты.

Клиникасы
Ол ыстық көтеріліп, қалтырап дірілдеуден басталуы мүмкін, бірақ әдетте бірте-бірте, тез шаршау, әлсіздіқ асқа тәбеттің болмауы, бастың асқазанның буындардың ауыруы формасында өрбиді.
Ыстықтың көтерілуі жеңіл және ауыр формада болуы мүмкін. Түстен кейін қалтырап-дірілдеу және ертеңгісін малшынып терлеп қалу бұл ауруға тән белгі. Созылмалы бруцеллёзде ыстық бірнеше күн басылады да сосын қайта көтеріледі. Тиісті ем қолданбаса, бірнеше жылға созылуы мүмкін.
Мойында, қолтықтың астында, шапта ісінген лимфа түйіндері пайда болуы мүмкін.

Диагностикасы
бактериологиялық: гемакультура жұлын сұйықтығы, синовиальды сұйықтықты қолдану
биологиялық (теңіз шошқаларын зақымдау)
иммунды ферментті анализді антиген, антидене табу үшін
агрегатгемаглютинация әдісі (АГАР)
серологиялық әдіс: комплемент байланыстыру реакциясы (КБР)
аллергиялық әдіс (ГЗТ) -Бюрне сынамасы

Балау. Зертханаға бактериологиялық тексеру үшін тастанды төлді ұрық қабығымен бірге немесе төлдің қарнын екі жағын буып ішіндегісімен бауыр, көк бауырдың кесінділерін, енін қосалқысымен бірге, жатырдың өзгеріске ұшыраған тұстарынан кесінді жəне сөл тұйіндерін жібереді.
Бактериологиялық диагноз қою үшін жағындыны микроскоппен қарап, ауру қоздырғышының таза өсіндісін бөліп алады, ауру қоздырғышының өсіндісінен езінді жасап теңіз шошқасына биологиялық сынама қояды.

Серологиялық реакциялар бруцеллезге жаппай тексеру үшін қолданылады. Бұлардың ішінде ең танымал əдістері. Агглютинация реакциясы, комплемент байланыстыру реакциясыкомплементті ұзақ байланыстыру реакциясы сонымен қатар Розбенгал сынамасы.

Аллергиялық тексеру үшін бруциллин аллергені қолданылады. Оны тері ішіне немесе тері астына жібереді.

Назарларыңызға рахмет!!!
- Іс жүргізу
- Автоматтандыру, Техника
- Алғашқы әскери дайындық
- Астрономия
- Ауыл шаруашылығы
- Банк ісі
- Бизнесті бағалау
- Биология
- Бухгалтерлік іс
- Валеология
- Ветеринария
- География
- Геология, Геофизика, Геодезия
- Дін
- Ет, сүт, шарап өнімдері
- Жалпы тарих
- Жер кадастрі, Жылжымайтын мүлік
- Журналистика
- Информатика
- Кеден ісі
- Маркетинг
- Математика, Геометрия
- Медицина
- Мемлекеттік басқару
- Менеджмент
- Мұнай, Газ
- Мұрағат ісі
- Мәдениеттану
- ОБЖ (Основы безопасности жизнедеятельности)
- Педагогика
- Полиграфия
- Психология
- Салық
- Саясаттану
- Сақтандыру
- Сертификаттау, стандарттау
- Социология, Демография
- Спорт
- Статистика
- Тілтану, Филология
- Тарихи тұлғалар
- Тау-кен ісі
- Транспорт
- Туризм
- Физика
- Философия
- Халықаралық қатынастар
- Химия
- Экология, Қоршаған ортаны қорғау
- Экономика
- Экономикалық география
- Электротехника
- Қазақстан тарихы
- Қаржы
- Құрылыс
- Құқық, Криминалистика
- Әдебиет
- Өнер, музыка
- Өнеркәсіп, Өндіріс
Қазақ тілінде жазылған рефераттар, курстық жұмыстар, дипломдық жұмыстар бойынша біздің қор #1 болып табылады.



Ақпарат
Қосымша
Email: info@stud.kz